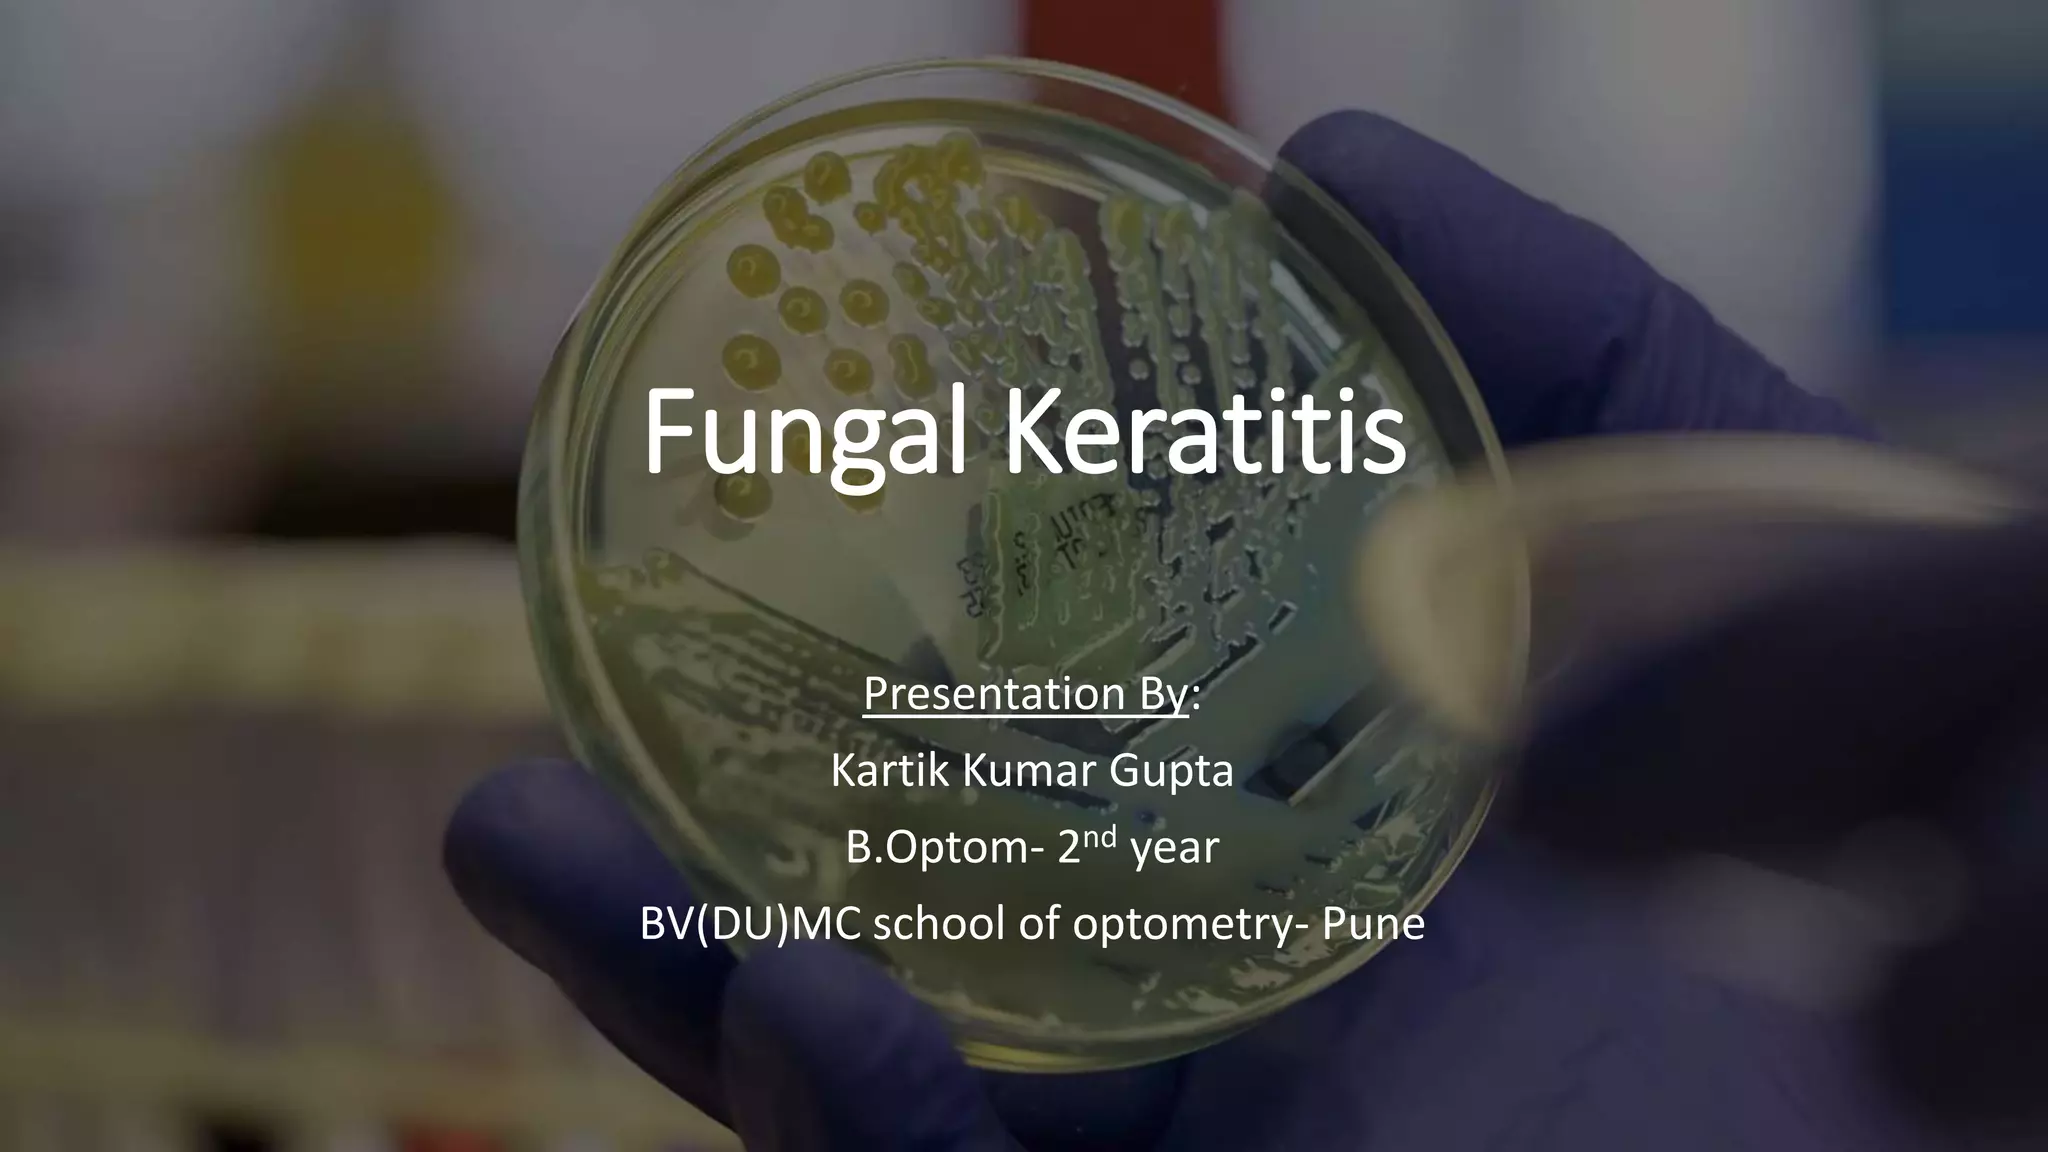

Fungal keratitis is a fungal infection of the cornea that is common in developing nations. It is most often caused by filamentous fungi like Aspergillus, Fusarium, and Curvularia in tropical areas, and Candida species in temperate regions. Risk factors include corneal injury, topical steroid use, diabetes, and contact lens use. Symptoms include pain, blurred vision, photophobia, and corneal ulceration. Diagnosis involves corneal scraping and culture, though PCR is more rapid. Treatment consists of topical antifungals like natamycin, amphotericin B, or voriconazole, with systemic antifungals as adjunctive therapy for severe cases